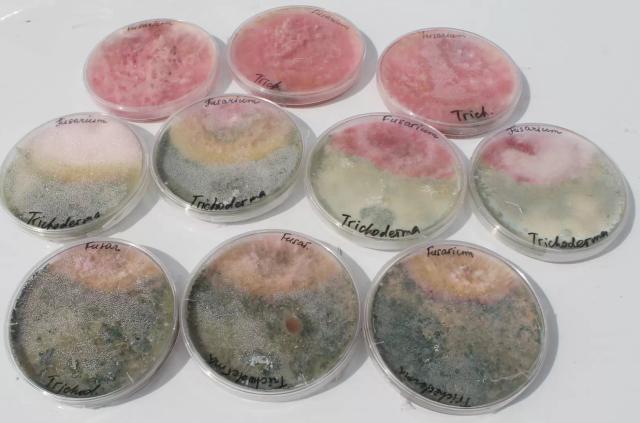

«Цветение» почвы или роль альгофлоры в здоровье почв
Сегодня мне бы хотелось поговорить о .. водорослях, но не тех, которых мы видим поздним летом в озере или мелководной реке – а о почвенных водорослях ,которые играют колоссальную роль в формировании в здоровье почв.
Введение
«Цвегение» почвы — это эпизодически - регулярное явление, связанное с бурным размножением на поверхности водорослей и цианобактерии.
«Цветение» почвы - не просто скопление особей на ограниченной территории. Это сообщества, в которых различные группы фототрофов в зависимости от сезонной и флуктуационной ситуации меняют количественные соотношения с формированием доминирующих видов с контрастными эколого-биологическими свойствами.
«Цветения» почвы характеризуется наличием тесных, классических типов фототрофов с гетерогрофными партнёрами на уровне физических, трофических и аллелопатических контактов, во многом сходных с фитоценотическими.
Локусы «цветения» - центры повышенной биогенной активности благодаря первичной продуктивности фототрофных микроорганизмов и скорости её обновления и трансформации.
Интенсивность, видовой состав и длительность «цветения» определяются внутрипочвенным пулом фототрофов, реализация которого на поверхности зависит от климатических, пючвенных условий и системы агроприёмов при возделывании той или другой культуры.
Феномен «цветения» почвы отражает се состояние, определяя уровень. биогенных элементов как при их исчерпании, так и при избытке.
Используя структурно-групповой анализ поверхностных разрастаний, можно определить необходимость удобрения почвы или, наоборот, её детоксикации для возделывания сельскохозяйственных растений.
Роль и функции водорослей в почвах
Развиваясь на поверхности и в толще почвы, водоросли:
- оказывают влияние на физико-химические свойства почвы,
- изменяют рН почвенного раствора,
- улучшают водный режим и аэрацию почвы, препятствуют ее эрозии – за счет формирования органического вещества,
- через избирательное поглощение и концентрирование в своих клетках отдельных химических элементов, в том числе и радиоактивных, влияют на солевой баланс и состав микроорганизмов в почве,
- многие виды сине-зеленых водорослей (цианобактерий) способны к азотфиксации. За счет азотфиксации сине-зеленых водорослей накопление азота для почв умеренной зоны составляет от 2 до 51 кг/га в год,
- большая часть биомассы, сформированной почвенными водорослями, используется разнообразными организмами, получающими от них не только энергетический материал, но и ряд физиологически активных веществ. В результате этого усиливается общая биологическая активность почвы, повышается ее плодородие. почвенные альгоценозы являются высокомобильным компонентом почвенной микрофлоры, они способны производить в месяц до 700 г/м2 продукции, а время обновления их биомассы может составлять от 1 до 7 суток,
- водоросли разных таксономических групп способны синтезировать практически все известные фитогормоны, причём в концентрациях, сравнимых с их содержанием в высших, эти факты свидетельствуют о возможности стимулирования роста сельскохозяйственных культур и повышения их продуктивности,
Полученные результаты согласуются с мнением, что высокое содержание в почве водорослей отражает её плодородие и оптимальный статус здоровья почв.
Оценка сообществ водорослей
Для оценки сообществ водорослей используют множество классификационных подходов, которые можно разделить на две основные группы: эколого-флористические и физиономические.
На данный момент оба подхода широко распространены и во многом дополняют
друг друга, хотя ведущая роль принадлежит эколого-флористическому направлению, близкому к
системе классификации растительности по Браун-Бланке.
Как водоросли помогают ремедиации зон с токсичными субстратами
Сукцессии водорослей на токсичных субстратах идут по модели стимулирования, когда каждые поселяющиеся виды улучшают условия для поселения новых. Схематично это выглядит следующим образом. На поверхность токсичного субстрата заносятся различные водоросли, часть из которых погибает, другая остается в неактивном состоянии и только некоторые, способные вегетировать в данных условиях, начинают развиваться. В процессе жизнедеятельности клетки водорослей выделяют одни вещества, в том числе и химически активные (кислоты, щелочи,ферменты и т.д.), и поглощают другие. За счет указанных процессов около клеток возникают зоны с ослабленной токсичностью субстрата. В таких зонах поселяются бактерии, микроскопические грибы, простейшие, которые вместе с водорослями образуют микроскопическую консорцию. Такая консорция представляет собой своеобразное «пятно жизни» на поверхности токсичного безжизненного субстрата. Функционирование микроконсорции приводит к расширению размеров «пятна жизни» и дальнейшему заселению ее новыми видами водорослей, увеличению флористического разнообразия альгоценоза. В зонах с постоянно снижающейся токсичностью продолжается колонизация субстрата с участием как автотрофных, так и гетеротрофных организмов.
Альгогенозы в агроценозах
Исследования альгоценозов пока носят отрывочный характер. Например, в агроценозах Краснодарского края основу видового разнообразия формируют зеленые водоросли и цианобактерии. Среди них доминировали виды цианобактерий: Oscillatoria amphibia Ag., Phormidium inundatum Kütz., зеленые водоросли: Chlorococcum infusionum Menegh.,
Chlorella vulgaris Beyer., характерные для черноземов луговых степей, а также Chlamydomonas minutissima Korsch. и диатомовые Hantzchia virgata (Roper.) Grun. Довольно высокой в годы исследований была численность Chlorosarsina minor Gerneck. Полученные результаты согласуются с мнением, что высокое содержание в почве водорослей отражает её плодородие.
Так же, установлена и описана и роль цианобактерий в супрессивности почв – об этом мы поговорим в следующих постах
Справочная информация
Сине-зеленые водоросли (цианобактерии). По образу жизни и жизненным формам сине-зеленые более близки к водорослям, чем к бактериям, это единственные прокариоты, осуществляющие фотосинтез с выделением кислорода.
Физиологические особенности сине-зеленых водорослей проявляются в сочетании таких процессов, как фотосинтез с выделением кислорода, отсутствие истинного дыхания, способность к азотфиксации и переключение с фототрофного на гетеротрофный обмен. Среди сине-зеленых водорослей есть крайние термофилы, и крайние термофобы. Сине-зеленые водоросли часто выступают пионерами заселения мест с экстремальными для жизни условиями. Многие из них вступают в ассоциацию с грибами, образуя лишайники.
Зеленые водоросли – самый обширный отдел водорослей Chloropiiyta, которые обычны среди почвенной биоты. Они легко узнаются по чисто-зеленому цвету, хотя не образуют, как сине-зеленые, больших поверхностных корочек, пленок и другого типа разрастаний. Их от-дельные клетки или нитчатые талломы распределяются в верхнем слое почвенной толщи и иногда придают почве зеленоватый оттенок. По морфологии клетки и организации таллома зеленые водоросли очень разнообразны . Одноклеточные формы (порядок Chlorococcales) бывают круглыми, серповидными, веретеновидными; иногда они собраны в агрегаты из 3–4 клеток. Размножаются зеленые водоросли делением, образованием бесполых спор – неподвижных (автоспоры) и подвижных (зооспоры).
Желто-зеленые водоросли – менее разнообразны, но не менее многочисленные в почве, чем зеленые. Они часто вызывают «цветение» на торфе. Желто-зеленые водоросли представлены в почве одноклеточными и нитчатыми формами.
Диатомовые водоросли. Название их – Diatomeae – происходит от латинских слов «di» – два и «toma» – делить, т. е. разделенные на два. Это связано со своеобразным строением их оболочки, которая состоит из двух половин. Между двумя створками их «раковинки», построенной из кремнезема, проходит шов (поясок) с узелками. Через этот шов протопласт может соприкасаться с субстратом, и клетка передвигается по нему благо-даря особому току протоплазмы. Клеточные оболочки имеют характерный для каждого вида рисунок, благодаря которому эти водоросли легко иден-тифицировать. Так как их панцири, пропитанные кремнеземом, сохраня-ются в почве очень долго, то по ним пытаются определить возраст отло-жений. Хроматофоры диатомей имеют бурый или желтоватый цвет. Все диатомовые водоросли – одноклеточные формы.
При подготовке сообщения были использованы открытые литературные источники:
"ЦВЕТЕНИЕ" ПОЧВЫ В АГРОЭКОСИСГЕМАХ И ЗАКОНОМЕРНОСТИ ЕГО РАЗВИТИЯ, Дормачева Л.И. 1998
Цианобактериально-водорослевые ценозы почв урбанизированных территорий Южно-Уральского региона, Суханова Н.В., 2016
ПОЧВЕННЫЕ ВОДОРОСЛИ: КАЧЕСТВЕННЫЙ СОСТАВ, КОЛИЧЕСТВЕННЫЕ ХАРАКТЕРИСТИКИ,ИСПОЛЬЗОВАНИЕ ПРИ ПРОВЕДЕНИИ ЭКОЛОГИЧЕСКОГО МОНИТОРИНГА Кабиров Р.Р., Пурина Е.С., Сафиуллина Л.М.
2008
РОЛЬ ПОЧВЕННЫХ ВОДОРОСЛЕЙ В АНТРОПОГЕННЫХ ЭКОСИСТЕМА, Кабиров Р.Р.2007
ОСОБЕННОСТИ ВОССТАНОВЛЕНИЯ ГРУППИРОВОК ПОЧВЕННЫХ ВОДОРОСЛЕЙ НА КОСТРИЩАХ, Бачура Ю. М. , 2008
ВИДОВОЙ СОСТАВ АЛЬГОФЛОРЫ АГРОЦЕНОЗОВ КУБАНИ, Доценко К. А., Федулов Ю.П., 2017
БИОЛОГИЯ ПОЧВ, Клебанович Н.В., Ефимова И.А.,Д. А. Чиж Д.А., 2017
АЛЬГОЛОГИЧЕСКИЙ МОНИТОРИНГ ПАХОТНЫХ ДЕРНОВО-ПОДЗОЛИСТЫХ ОГЛЕЕННЫХ ПОЧВ В ОЦЕНКЕ ЭФФЕКТТВНОСТИ АГРОМЕЛИОРАТИВНЫХ МЕРОПРИТИЙ, Кондакова Л.В., 2010

1 комментарий